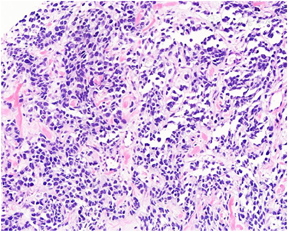

患者男,22岁。因"右腰痛3天"入院就诊。
患者3天前无明显诱因及前驱症状下出现右腰痛,呈持续性绞痛,进行性加重,较剧难忍,放射至下腹部,无血尿,无尿频、尿急、尿痛。
急诊查泌尿系CT示:右侧盆腔膀胱旁软组织影,膀胱壁右侧局部增厚,前列腺增大、右后方精囊腺结构不清,右侧肾盂及输尿管积水。入院后行MRI检查:右侧盆腔为主占位伴膀胱右侧壁受累,两侧精囊腺显示不清,肿瘤可能性大。进一步行B超引导下经会阴前列腺及精囊腺旁肿物穿刺活检术。经病理检查及荧光原位杂交(FISH)分别检测PAX3和FOXO1基因分离均阳性,明确诊断为前列腺腺泡状横纹肌组织肉瘤。
患者明确诊断后转院进一步行口服安罗替尼靶向药物治疗。
2个月后发现全身多发淋巴结转移及骨转移;6个月后患者死亡。
病理科;泌尿外科;肿瘤科

版权归中华医学会所有。本文为遵循CC-BY-NC-ND协议的开放获取文章。
横纹肌肉瘤(rhabdomyosarcoma, RMS)是一种显示原始骨骼肌分化的原始间叶性恶性肿瘤。前列腺横纹肌肉瘤是儿童/婴幼儿最常见的前列腺恶性肿瘤,罕见发生于成年人;组织学类型中,最常见的是胚胎性横纹肌肉瘤,其次是腺泡状横纹肌肉瘤。前列腺腺泡状横纹肌肉瘤呈高度侵袭性,国内外文献中较少报道,本文报道1例成人原发前列腺腺泡状横纹肌肉瘤,结合相关文献复习其临床病理学特征以及预后特点;旨在准确识别该类肿瘤组织学类型及分子遗传学改变,更好地指导临床治疗和判断预后。
患者男,22岁。因"右腰痛3天"入院就诊。患者3天前无明显诱因及前驱症状下出现右腰痛,呈持续性绞痛,进行性加重,较剧难忍,放射至下腹部,无血尿,无尿频、尿急、尿痛。急诊予以解痉止痛治疗后疼痛缓解。患者未婚未育,无相关特殊家族史、冶游史、手术史。
肛门指检:肛管内壁光滑,距肛门4cm处可触及约2.0×2.0cm肛管外侧占位,质硬,稍有触痛。急诊查泌尿系CT示:右侧盆腔膀胱旁软组织影,膀胱壁右侧局部增厚,前列腺增大、右后方精囊腺结构不清,右侧肾盂及输尿管积水。入院后行MRI检查:右侧盆腔为主占位伴膀胱右侧壁受累,两侧精囊腺显示不清,肿瘤可能性大(图1)。进一步行B超引导下经会阴前列腺及精囊腺旁肿物穿刺活检术。


病理检查:送检双侧前列腺穿刺组织8条(左1至左4、右1至右4各一条),长度0.2cm~1.5cm,直径均为0.1cm。镜下观察:其中左2至左4可见良性前列腺腺体,其余5条均为纤维肌性脂肪组织,8条组织内均可见多灶呈小巢、片状以及腺泡样结构的幼稚深染短梭形或卵圆形肿瘤细胞增生、浸润(图2,图3),瘤细胞胞质稀少,核不规则,染色质深,核分裂象和凋亡小体多见,偶见胞质强嗜酸性的横纹肌母细胞样细胞,间质可见带状胶原纤维沉积和局灶的黏液变性(图4,图5)。免疫组织化学染色:肿瘤细胞弥漫核表达MyoD1(图6),大部分表达Myogenin(图7),部分表达结蛋白,弥漫表达CD56,Olig-2局灶表达,约5%(图8),ALK个别细胞表达,弥漫胞质表达WT1和波形蛋白,S-100蛋白阴性,Ki-67增殖指数约70%。荧光原位杂交(FISH)分别检测PAX3和FOXO1基因分离:PAX3和FOXO1基因重排均阳性(图9,图10)。


















病理诊断:前列腺腺泡状横纹肌肉瘤。
患者明确诊断后转院行口服靶向药物盐酸安罗替尼胶囊7个疗程(10mg qd po d1-14, q3w)控制病情,期间行B超引导下肾造瘘解除梗阻情况、补充电解质维生素等对症支持治疗。
随访2个月患者多发淋巴结转移及骨转移,6个月后死亡。
横纹肌肉瘤(rhabdomyosarcoma, RMS)是具有原始骨骼肌分化的形态学、免疫组织化学、超微结构或分子遗传学表现的恶性肿瘤,通常缺乏其他成分分化。2020年新版软组织与骨肿瘤WHO分类中将横纹肌肉瘤分为:胚胎性横纹肌肉瘤、腺泡状横纹肌肉瘤,多形性横纹肌肉瘤,梭形细胞/硬化性横纹肌肉瘤和外胚层间叶瘤。此外,还有未收入的上皮样横纹肌肉瘤,新近报道的炎症性横纹肌母细胞性肿瘤。横纹肌肉瘤是儿童/婴幼儿最常见的软组织肉瘤,常见发病部位是头颈部、躯干(包括泌尿生殖道)和四肢。前列腺横纹肌肉瘤是儿童/婴幼儿最常见的前列腺恶性肿瘤,罕见发生于成年人,成人原发性RMS占所有前列腺恶性肿瘤<1%[1]。组织学类型中,最常见的是胚胎性横纹肌肉瘤(embryonal rhabdomyosarcoma, ERMS),大约占60%的前列腺横纹肌肉瘤;腺泡状横纹肌肉瘤(alveolar rhabdomyosarcoma, ARMS)是第二常见的组织学类型,大约占15%~20%,梭形细胞型和胚胎性横纹肌肉瘤间变亚型罕见[2]。回顾文献[3]发现报道的具有腺泡状形态的前列腺横纹肌肉瘤有6例,4例诊断为腺泡状横纹肌肉瘤,年龄6周至48岁,1例6岁儿童诊断为混合性胚胎性/腺泡状横纹肌肉瘤;另1例28岁男性最初诊断为混合性胚胎性/腺泡状横纹肌肉瘤,后经分子检测证实为腺泡状横纹肌肉瘤。ERMS与ARMS预后差异明显,因此应准确加以区分。
ARMS在组织形态上有三种类型:经典型、实体型和胚胎型-腺泡状混合型。经典型ARMS典型的病理特征是成片或巢状的小圆细胞被纤维血管间质分隔,巢中央的瘤细胞常因发生退变和坏死失去黏附性而脱落,或漂浮在腺泡腔内,形成特征性的腺泡状结构,与ERMS不同的是,ARMS中可见部分肿瘤细胞核位于嗜酸性胞质周边,可形成特征性的多核瘤巨细胞。实体型ARMS由弥漫成片分布的小圆细胞组成,呈实性胚胎样生长结构,腺泡状结构或纤维血管性间隔均不明显,肿瘤细胞无明显的横纹肌分化;所以实体型ARMS与致密ERMS镜下形态鉴别常存在一定困难,实体型ARMS肿瘤细胞形态呈单一形态的圆细胞伴有泡状染色质和不显著的核仁;致密ERMS肿瘤细胞形态呈成角的细胞核和大小不等的显著的核仁。胚胎性-腺泡状混合型除具有典型的ARMS病理特征外,局部区域显示ERMS的形态,可以看到不同分化阶段的横纹肌母细胞;但不推荐使用混合性胚胎及腺泡状横纹肌肉瘤,这类肿瘤多数缺乏PAX3/7-FOXO1融合基因,这些具有腺泡状型生长模式的融合蛋白阴性横纹肌肉瘤病例在基因表达特征、全染色体拷贝数变化和临床生物学行为方面与ERMS没有区别[4,5],因此更接近ERMS。
免疫组织化学ARMS主要表达肌源性标志物结蛋白、myogenin和MyoD1,应用免疫组织化学在实体型ARMS和致密ERMS鉴别诊断中有一定帮助:(1)myogenin在ARMS中肿瘤细胞核呈弥漫强阳性,ERMS常呈局灶阳性;myogenin强弥漫表达与PAX3/7-FOXO1易位密切相关[6,7,8]。(2)69%~81%的ARMS可不同程度地表达ALK[9],可能呈局灶阳性;ERMS通常阴性(阳性率为6%-32%)。(3)新近文献报道OLIG2是ARMS中融合蛋白驱动的神经发育转录信号的标志物,有助于基因融合阳性病例的诊断和判断预后[10]。Olig-2在ARMS通常阳性(FOXO1重排横纹肌肉瘤病例中约96%阳性),可能仅局灶表达,ERMS通常阴性。本例Olig-2呈局灶表达。(4)最近的一篇文献报道MUC4在大多数PAX3/7- FOXO1融合阳性ARMS中有不同程度的表达,而在其他横纹肌肉瘤亚型中罕见表达[11]。(5)PAX5也有助于识别基因融合阳性的ARMS[12]。此外,除MUC4外,ARMS表达其他一些上皮分化特征的标志物,例如,大约一半ARMS表达广谱角蛋白,横纹肌肉瘤偶尔也表达突触素, chromogranin A和INSM1,可被误诊为小细胞癌或差分化神经内分泌癌。ARMS还可程度不等地表达CD99,易误诊为原始神经外胚层肿瘤。因此免疫组织化学标记有时可能会是诊断陷阱,病理医师应避免误诊或漏诊。据文献报道,80%的ARMS病例存在染色体易位,其中60%病例表现为t( 2 ;13)(q35;q14),导致PAX3-FOXO1融合,20%的病例为t(1;13)(p36;q14),导致PAX7-FOX01融合基因[13]。这些异常在核型上与ERMS中常见的11p15.5杂合性丢失差别很大。
大多数前列腺横纹肌肉瘤诊断明确,但在实体型ARMS和致密ERMS组织学亚型鉴别诊断中有时存在一定困难,尤其是在穿刺小活检标本中,实际工作中可通过结合肿瘤细胞形态、免疫组织化学及分子检测明确类型。ARMS还需与累及前列腺的其他小圆细胞肿瘤鉴别:(1)前列腺低分化癌:多见中老年患者,可见不同分化区域,表达多种上皮性标志物,不表达肌源性标志物。(2)前列腺神经内分泌癌:多见于前列腺癌患者抗雄治疗后,有独特的神经内分泌癌组织学形态和细胞核特征,表达神经内分泌标志物,不表达肌源性标志物。(3)淋巴瘤:肿瘤细胞多弥漫分布,表达相应的B或T细胞标志物。(4)骨外尤因肉瘤:瘤细胞可分叶状或片状分布,较少见到腺泡状结构,肿瘤细胞成分相对单一,部分病例可见菊形团结构,瘤细胞胞膜常弥漫强表达CD99,表达NKX2.2,偶可灶性表达desmin,但不表达myogenin和MyoD1,存在EWSR1-FLI1融合基因或EWSR1基因相关易位。(5)促结缔组织增生性小圆细胞肿瘤:高度恶性的小圆细胞恶性肿瘤,伴大量增生致密的纤维结缔组织,免疫组化显示多向性分化,Demin和Vimentin特征性的核旁点状阳性,90%以上的病例存在EWSR1-WT1融合基因。(6)小细胞差分化的滑膜肉瘤:多发生在大关节附近,腹腔内极少发生。瘤细胞表达AE1/AE3、EMA和BCL-2,不表达Desmin。90%以上的病例可检测出SSI8基因相关易位。(7)肾外恶性横纹肌样瘤:由不相黏附的巢状或实性片状的横纹肌样细胞组成,肿瘤细胞核仁明显,胞质丰富可见嗜酸性包涵体,免疫组织化学INI1表达缺失。(8)其他肿瘤:包括恶性黑色瘤、恶性间皮瘤、胃肠道间质瘤等。
前列腺横纹肌肉瘤患者年龄不同,预后差异显著。接受化疗联合或不联合放疗及手术治疗的儿童和青少年的长期生存率为60%至70%。大多数确诊为前列腺横纹肌肉瘤的成年患者在治疗后2年内死亡。前列腺ARMS呈浸润性生长,恶性度高,早期易复发转移,预后明显差于ERMS;文献报道的6例具有腺泡状形态的前列腺横纹肌肉瘤,4例有随访结果,3例死于肿瘤,其中2例分别于6个月、9个月死亡。本例患者明确诊断后6个月死于肿瘤。此外,文献报道携带PAX3-FOXO1融合基因是一个不利的预后因素[14]。因此准确识别肿瘤组织学类型及分子遗传学检测能够更好地指导临床治疗和判断预后。
所有作者均声明本研究不存在利益冲突